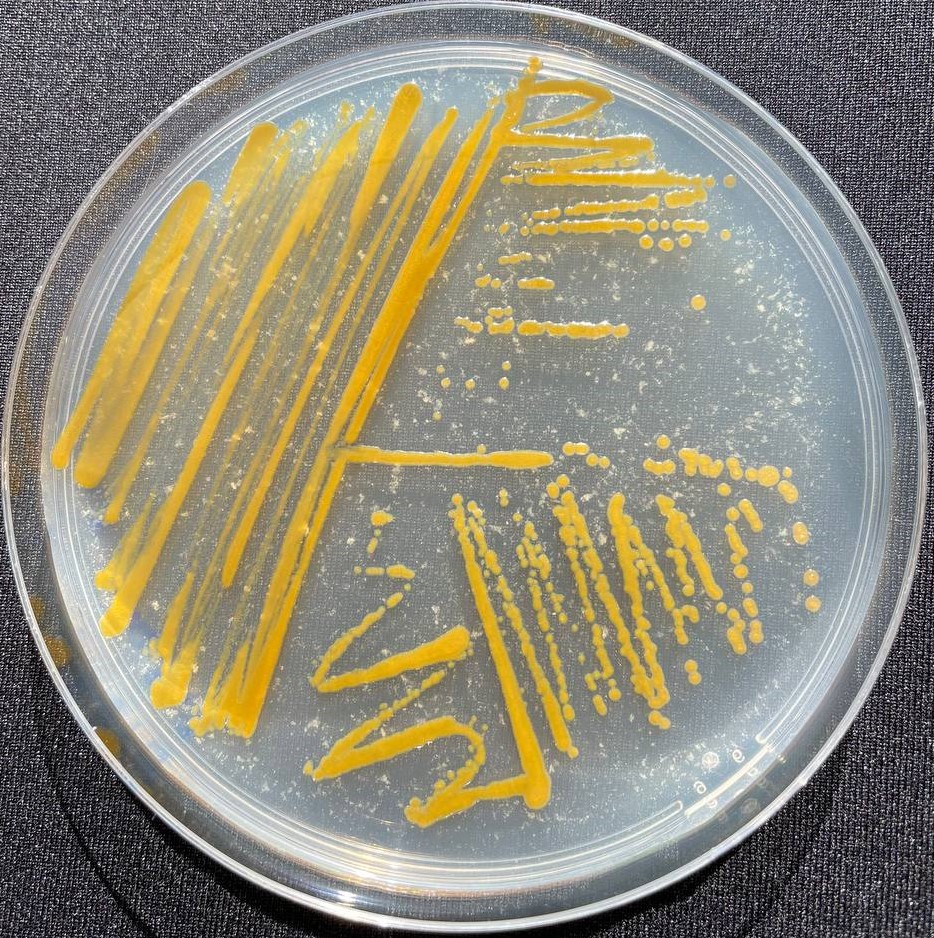

Your cart is currently empty!
| Country: | Portugal |
|---|---|
| Biome or Habitat: | North-East Atlantic Ocean (wild) |
| Specific Locality: | Galé Alta, Algarve |
| Latitude: | 37.06933300 |
| Longitude: | -8.33113900 |
| Depth: | 15m |
| Sampling Date: | 10 June, 2010 |
| Collector(s): | Jorge Gonçalves, Carlos Afonso |
| Strain Code: | Aq78 |
|---|---|
| Isolator: | Ana Esteves |
| DOI: | http://10.1111/1462-2920.14747 |
|---|---|
| DOI: | http://10.1111/1574-6941.1214010.3390/md20070423 |
| DOI: | http://10.3390/md21010034 |
| 16S: | HE818244 |
|---|---|
| Genome: | GCA_900299525.1 |
| Genome: | GCA_943416075.1 |
| Specimen State: | Criopreservado |
|---|